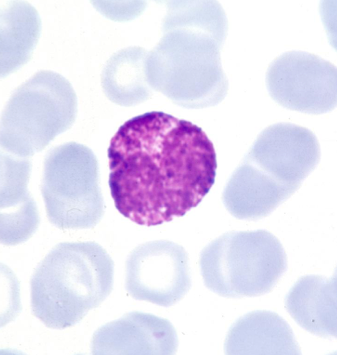
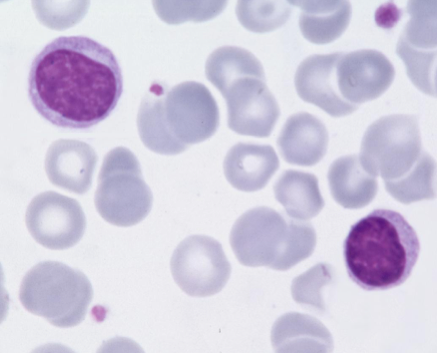

What is the name of this cell and how prevalent is it in blood? (2)
Basophil (about 1%)
What is the name of these cells and how prevalent are they in blood?

Eosinophils (around 3%)
What is the name of this cell and how prevalent is it in blood?
Lymphocyte (around 28%)
What is the name of this cell and how prevalent is it in blood?

Monocytes (around 8%)
What is the name of this cell and how prevalent is it in blood?

Neutrophils (around 60%)
What would cause an increase in the percentage of neutrophils?
- Stress
- physiological or pathological
- acute infection
- trauma
- infarction
- inflammation
- Steroids can cause demargination
What would cause an increase in the percentage of eosinophils?
- Parasitic infections
- hypersensitivity/ allergic reactions
What would cause an increase in the percentage of basophils?
- hypersensitivity reactions
What do red cells have instead of a nucleus?
Hb
What does a lack of iron or B12 do to red cells? (MCV)
It can alter their size
What does lower Hb suggest?
Anaemia
an=without
aemia=blood
What type of anaemia does a patient have if it presents on a microcytic level?
iron deficiency!
e.g. chronic blood loss
What type of anaemia does a patient have if it presents on a macrocytic level?
Vitamic B12/ folate deficiency
(nuclear defects)
What type of anaemia does a patient have if it presents on a normocytic level?
- Acute blood loss
- Anaemia of chronic disease (eg inflammation, infection)
What other changes may chronic disease anaemia cause in blood results?
Changes in
- iron homeostasis
- the proliferation of erythroid cells
- the production of erythropoeirin
- the life span of red cells
What would you worry about if a patient has a high Hb level?
- False result- dehydration
- Secondary cause- hypoxia driven
- Primary- bone marrow disorder
What additional abnormalities can blood films indentify (that analysers cannot)?
- target cells in liver disease
- red cell fragmentation
- reflecting mechanical damage
What would cause an increase in the percentage of monocytes?
- chronic infections
- malignancy
- autoimmune disorders
What would cause an increase in the percentage of Lymphocytes?
- Viral infections
- eg glandular fever, ‘reactive’ or activated lymphocytes
What aspects of plasma are you interested in?
- Coagulation proteins
- Plasma viscosity
What is haemostasis?
The arrest of bleeding and the maintenance of vascular patency
What are the four requirements of haemostasis?
- Permanent state of readiness
- Prompt response
- Localised response
- Protection against unwanted thrombosis
What are the four components of a regular haemostatic system?
- Formation of platelet plug
- primary haemostasis
- Formation of fibrin clot
- secondary haemostasis
- Fibrinolysis
- Anticoagulant defences
What kind of cells are platelets?
Small anucleate discs


